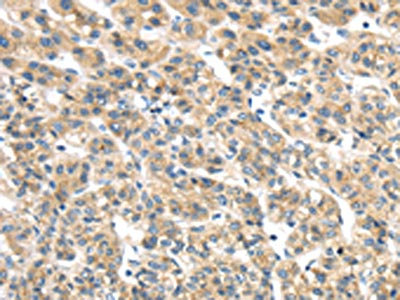

-
中文名稱:TMED2兔多克隆抗體
-
貨號:CSB-PA277474
-
規格:¥1100
-
圖片:
-
The image on the left is immunohistochemistry of paraffin-embedded Human liver cancer tissue using CSB-PA277474(TMED2 Antibody) at dilution 1/25, on the right is treated with fusion protein. (Original magnification: ×200)
-
The image on the left is immunohistochemistry of paraffin-embedded Human esophagus cancer tissue using CSB-PA277474(TMED2 Antibody) at dilution 1/25, on the right is treated with fusion protein. (Original magnification: ×200)
-
-
其他:
產品詳情
-
Uniprot No.:
-
基因名:TMED2
-
別名:coated vesicle membrane protein antibody; Membrane protein p24A antibody; p24 antibody; p24 family protein beta-1 antibody; P24A antibody; p24beta1 antibody; RNP24 antibody; Sid 394 antibody; Sid394 antibody; TMED2 antibody; TMED2_HUMAN antibody; transmembrane emp24 domain trafficking protein 2 antibody; Transmembrane emp24 domain-containing protein 2 antibody
-
宿主:Rabbit
-
反應種屬:Human,Mouse,Rat
-
免疫原:Fusion protein of Human TMED2
-
免疫原種屬:Homo sapiens (Human)
-
標記方式:Non-conjugated
-
抗體亞型:IgG
-
純化方式:Antigen affinity purification
-
濃度:It differs from different batches. Please contact us to confirm it.
-
保存緩沖液:-20°C, pH7.4 PBS, 0.05% NaN3, 40% Glycerol
-
產品提供形式:Liquid
-
應用范圍:ELISA,IHC
-
推薦稀釋比:
Application Recommended Dilution ELISA 1:2000-1:5000 IHC 1:25-1:100 -
Protocols:
-
儲存條件:Upon receipt, store at -20°C or -80°C. Avoid repeated freeze.
-
貨期:Basically, we can dispatch the products out in 1-3 working days after receiving your orders. Delivery time maybe differs from different purchasing way or location, please kindly consult your local distributors for specific delivery time.
-
用途:For Research Use Only. Not for use in diagnostic or therapeutic procedures.
相關產品
靶點詳情
-
功能:Involved in vesicular protein trafficking. Mainly functions in the early secretory pathway but also in post-Golgi membranes. Thought to act as cargo receptor at the lumenal side for incorporation of secretory cargo molecules into transport vesicles and to be involved in vesicle coat formation at the cytoplasmic side. In COPII vesicle-mediated anterograde transport involved in the transport of GPI-anchored proteins and proposed to act together with TMED10 as their cargo receptor; the function specifically implies SEC24C and SEC24D of the COPII vesicle coat and lipid raft-like microdomains of the ER. Recognizes GPI anchors structural remodeled in the ER by PGAP1 and MPPE1. In COPI vesicle-mediated retrograde transport inhibits the GTPase-activating activity of ARFGAP1 towards ARF1 thus preventing immature uncoating and allowing cargo selection to take place. Involved in trafficking of G protein-coupled receptors (GPCRs). Regulates F2RL1, OPRM1 and P2RY4 exocytic trafficking from the Golgi to the plasma membrane thus contributing to receptor resensitization. Facilitates CASR maturation and stabilization in the early secretory pathway and increases CASR plasma membrane targeting. Proposed to be involved in organization of intracellular membranes such as the maintenance of the Golgi apparatus. May also play a role in the biosynthesis of secreted cargo such as eventual processing.
-
基因功能參考文獻:
- Surface plasmon resonance and solution NMR analyses revealed that p24beta1 and p24delta1 GOLD domains interact weakly (Kd= ~10(-4)M). PMID: 27569046
- TMED2/p24beta1 is expressed in all gestational stages of human placentas and in choriocarcinoma cell lines. PMID: 22212250
- Both p24A transmembrane protein and p23 are specific cargo receptors of G protein-coupled receptors (GPCR) and differentially regulate GPCR signaling in astrocytes. PMID: 21219331
- These results suggest that p24A is the limiting factor in CaSR trafficking in the early secretory pathway, and that cycling between the ER and ERGIC protects CaSR from degradation. PMID: 20361938
- p24A is a regulator of signal-dependent trafficking that controls ARF1-dependent resensitization of PAR-2 PMID: 17693410
顯示更多
收起更多
-
亞細胞定位:Cytoplasmic vesicle membrane; Single-pass type I membrane protein. Cytoplasmic vesicle, COPI-coated vesicle membrane; Single-pass type I membrane protein. Golgi apparatus, cis-Golgi network membrane; Single-pass type I membrane protein. Golgi apparatus, Golgi stack membrane; Single-pass type I membrane protein. Endoplasmic reticulum membrane; Single-pass type I membrane protein. Endoplasmic reticulum-Golgi intermediate compartment membrane; Single-pass type I membrane protein.
-
蛋白家族:EMP24/GP25L family
-
數據庫鏈接:
Most popular with customers
-
-
YWHAB Recombinant Monoclonal Antibody
Applications: ELISA, WB, IHC, IF, FC
Species Reactivity: Human, Mouse, Rat
-
Phospho-YAP1 (S127) Recombinant Monoclonal Antibody
Applications: ELISA, WB, IHC
Species Reactivity: Human
-
-
-
-
-